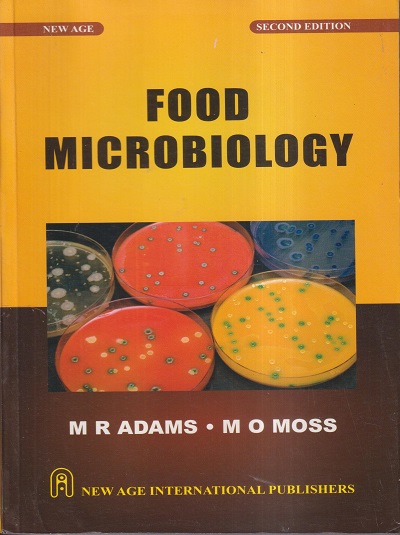
FOOD MICROBIOLOGY | M.R. ADAMS, M.O. MOSS | New Age

BSc / BSc CS / BSc CA / MSc CA / MSc CS Textbooks (Science)
1990 titles found

NEW (10%)
ENVIRONMENTAL CHEMISTRY | H. KAUR | GUPTA KUMAR SHARMA | PRAGATI PRAKASHAN MEERUT

NEW (10%)
A LOGICAL APPROACH TO MODERN ORGANIC CHEMISTRY | JAGDAMBA SINGH, S. ANANDVARDHAN | Pragati Prakashan, Meerut

NEW (10%)
PERICYCLIC REACTIONS & ORGANIC PHOTOCHEMISTRY | VINAY P. SHARMA | PRAGATI PRAKASHAN MEERUT

NEW (10%)
ADVANCE PHYSICAL CHEMISTRY | GURTU | PRAGATI PRAKASHAN MEERUT

NEW (10%)
MODERN ANALYTICAL CHEMISTRY | ALKA L. GUPTA | PRAGATI PRAKASHAN MEERUT

NEW (10%)
CLIMATOLOGY | SAVINDRA SINGH | Pravalika

NEW (15%)
AGRICULTURAL ENGINEERING QUESTION BANK | JAIVIR SINGH, VIKRANT KUMAR, PANKAJ KUMAR | JAIN BROTHERS

NEW (15%)
AGRICULTURAL ENGINEERING (SOLVED PAPERS OBJECTIVE TYPE) | P.K. NISHAD, S. MANGARAJ | JAIN BROTHERS

NEW (10%)
THEORETICAL APPROACHES IN FOOD SCIENCE AND TECHNOLOGY | ANJINEYULU KOTHAKOTA, R. PANDISELVAM | Jain Brothers
NEW (15%)
FOOD MICROBIOLOGY | M.R. ADAMS, M.O. MOSS | New Age

NEW (20%)
PLANT TAXONOMY | O.P. SHARMA | McGraw Hill

NEW (20%)
